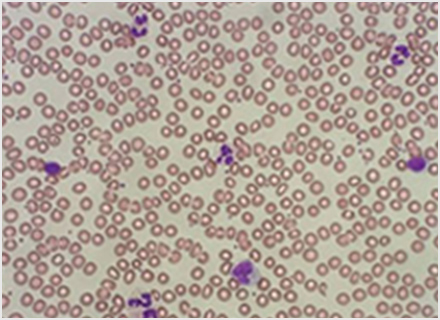
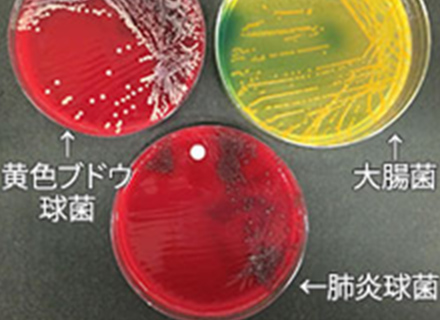

概要・特色
臨床検査とは、身体の構造や機能に関する様々な情報を調べることです。
臨床検査は、検体検査と生理機能検査に大別されます。検体検査は、血液、尿、便、組織細胞などの材料を、いったん体外に取り出してから検査します。
もう一つの生理機能検査は、患者さんの体に直接機器や器具を装着し検査を行います。
中央臨床検査部は、加藤部長を中心に全員が、検体検査部門・生理機能検査部門の双方で地域救急医療に貢献できる幅広い技能を持ち、検査部ならではの役割を果たすべく、日々努力しています。


部門構成
1号館3階
中央採血室、生理機能検査室
1号館4階
血液検査室、一般検査室、生化・免疫検査室、輸血検査室、細菌検査室、病理検査室
資格・認定
メンバー
- 細胞検査士:3名
細胞診スクリーニングの業務を正しく行いうることを認められたもの - 国際細胞検査士:2名
- 認定病理検査技師:1名
病理検査に関する専門知識やマネジメント能力を有する技術者 - 認定臨床微生物検査技師:1名
細菌検査における専門知識および高度な判定能力を有する技術者 - 認定輸血検査技師:1名
輸血検査における専門知識および高度な判定能力を有する技術者 - 糖尿病療養指導士:4名
自己血糖測定指導、糖尿病教室(集団、個別指導)、NSTに寄与 - 超音波検査士(循環器):4名
循環器領域における超音波検査の専門知識および高度な判定能力を有する技術者 - 排尿機能検査士:5名
前立腺がん全摘出患者のオペ前、後の検査。骨盤臓器脱オペ前検査、腹圧性尿失禁オペ前検査として、資格者が尿流動態検査を実施 - 緊急臨床検査士:3名
医師の監督指導のもとに緊急臨床検査の業務を担う - 認定救急検査士:1名
救急患者の診療において適時かつ適切に対応する知識と技術を有する - 健康食品管理士:1名
NSTへの参画
各種認定資格の取得にも積極的にチャレンジし、新人育成のための環境も整っています。
設備
中央採血室
診察前及び診察後検査の採血を行っています。
- 「本日のご予定」でEブロック受付にチェックがある時は、中央採血室[Eブロック]へお越しください。
- 「本日のご予定」をEブロックに提出してください。
- 尿検査がある方は、採尿カップをお渡しします。
- 採血のある方は、掲示板に受付番号が点灯したら入室してください。


採血までの流れ
受付
受付に「本日のご予定」を出してください。整理番号札をお渡しいたします。採血時にスタッフへ渡してください。
- 尿検査のある方(受付で採尿カップをお渡しいたします。)
- 次の案内まで、外待合でお待ちください。
ご案内
- 音声と掲示板でご案内します。
例)♪175番までの方は採血室にお入りください♪
※不在の場合は掲示板下部に番号が表示されますので、受付までお申し出ください。 - 掲示板に表示された番号までの方は、採血室の中待合で掛けてお待ちください。



採血
- 各採血台のモニターに整理番号が表示されます。整理番号札と「本日のご予定」をスタッフへ渡し、採血となります。採血で気分の悪くなる方・なったことのある方は、ベッドにて採血します。スタッフに声をかけてください。


生理機能検査室
生理検査室では、循環機能検査、神経機能検査、呼吸機能検査、耳鼻機能検査を行っています。
「本日のご予定」でFブロックにチェックがある時は、Fブロックへお越しください。
本日のご予定をFブロック受付に提出してください。


循環機能検査
心電図検査
心臓が動くときにおこるわずかな電気を波形として記録する検査です。狭心症、心筋梗塞や不整脈などの診断に役立てられます。
ホルター心電図検査
携帯型の心電計を使って日常生活の心電図を記録します。
記録中の行動や自覚症状を日記に記載し、24時間後に外します。不整脈の診断に役立てられます。
心臓超音波検査
超音波(聞こえない高い音)を心臓にあてその反射を画像にします。心臓の動きや壁の厚さ、
弁の構造、血液の流れ方などを観察し、さまざまな心疾患の診断に役立てられます。

血圧脈波検査
血圧を測ることにより動脈硬化症の診断を簡単に行うことができます。
神経機能検査
脳波検査
脳の微弱な活動電位を頭部につけた電極でとらえ、波形として記録し脳の働きを調べる検査です。てんかんの診断、けいれんや意識障がいの評価、睡眠異常の診断等に用いられます。
神経伝導検査
末梢神経を人工的に電気刺激することによって誘発される活動電位波形を記録し、伝導速度、振幅、持続時間などを測定します。末梢神経炎、手根管症候群などの診断に役立てられます。神経を電気刺激するため、軽い痛みを感じるかもしれませんが、体に害はありません
呼吸機能検査
患者さんの鼻をクリップでつまみ、マウスピースをくわえながら技師の声掛けで検査を進めていきます。呼吸器疾患の喚気障がい程度や治療効果判定、手術前、障がい認定などに用いられ、肺機能の全体像を考える上で基本的な検査です。
耳鼻機能検査
聴力検査、聴性脳幹反射などの耳の聞こえに対する検査や睡眠時無呼吸検査を行います。
血液検査
血液は、「赤血球」「白血球」「血小板」の3種類の血球と血しょうからできています。赤血球は酸素を運搬し、白血球は、体内に侵入した細菌やウイルスなどの外敵から体を守る働きをします。血小板は出血を止める働きを、血漿に含まれる凝固因子と呼ばれるタンパク質と共に行っています。血液は骨の中の骨髄と呼ばれる場所で作られます。血液検査はそれらに関わる状態を調べたり、異常を検出することができます。

一般検査
取り扱う検体は、尿、便、胸にたまる胸水、お腹にたまる腹水、心臓のまわりにたまる心嚢液、脳脊髄液などがあります。精液、関節液、鼻汁も含まれます。尿定性検査で尿タンパク、尿糖、尿潜血、白血球などを調べ、尿沈渣と言って、遠心沈殿させその成分を顕微鏡で観察します。便は、下部消化管出血を伴う大腸癌のスクリーニングや、寄生虫検査を行っています。脳脊髄液は緊急性の高い検査で髄膜炎の診断には欠かせない検査です。

生化・免疫検査室
生化・免疫検査室では、血清や体液などの検体の分析をはじめ、外注検査や血液ガス、B型肝炎、C型肝炎の抗原・抗体検査、梅毒、HIVを初めとする感染症、甲状腺機能検査、腫瘍マーカーなどの検査を行っています。24時間いつでも迅速で良質の検査が受けられる体制で稼働しています。




(遠心分離中)



輸血検査室
輸血検査室は、自動機器を導入し24時間安全な輸血療法が行えるよう、臨床検査技師が下記の輸血業務を行っています。

輸血検査
- 血液型検査(ABO式血液型・Rh式血液型)
- 交差適合試験(輸血を行う前の最終的検査)
- 不規則抗体スクリーニング(輸血副作用の原因となる抗体の有無の検査)
血液製剤の管理
- 血液センターへ血液製剤を発注し、納品後適正な温度での保管管理
- 交差適合試験で適合した血液製剤の払い出し
- 輸血後副作用の集計
- 科・病棟別返品率及び廃棄率の集計
自己血輸血の管理
自己血とは、手術時等に自分の血液を使用するために、事前に自分の血液を採取・保存することです。特に、緊急を要しない待機的手術、まれな血液で血液製剤の確保が難しい、副作用の既往歴がある場合等に適応となります。自己血は、購入不可能な血液のため、より慎重な保管・管理を行っています。
輸血前後の感染症検査のデータ管理
2008年7月から、輸血前・輸血後感染症のデータ管理を行い、名鉄病院で輸血療法を行い感染症に罹患した場合、生物由来製品感染等被害救済制度に迅速に対応できるよう、検査の実施状況・結果の管理を行っています。



細菌検査室
細菌検査室では臨床にて採取された各種検査材料(喀痰・糞便・尿・膿・鼻腔粘膜・咽頭粘膜など)を以下のように検査しています。

病原体の培養検査
結果の報告に3~7日程かかります。
塗抹検査
材料をスライドガラスへ塗抹します。塗抹標本を作成し、染色して顕微鏡で観察します。
培養検査
材料を専用の寒天平板培地に塗り、24~48時間・37℃で培養します。材料に含まれる菌を発育させます。

同定・薬剤感受性検査
培地に発育してきた菌を微生物自動分析装置にて分析します。菌の名前と薬剤感受性検査(どの薬が効くか)などを検査します。


迅速検査
迅速検査です。10~40分程で結果報告可能です。インフルエンザウイルス、RSウイルス、アデノウイルス、ロタウイルス、ノロウイルスなどのウイルスや肺炎球菌、レジオネラ、A群溶血連鎖球菌など各菌に対する迅速検査を行っています。また、クロストリジウム・ディフィシルの産生する毒素を検出する迅速検査も行っています。
院内感染対策
培養検査や迅速検査で得られた結果を臨床へ報告し、患者さんの感染症治療のサポートを行う一方、検査にて得られた結果・情報などを集計し、感染症の傾向や動向などの把握・感染症防止対策を目的として院内感染対策委員会にて報告しています。また、委員会活動では他職種(医師・薬剤師・看護師等)や近隣の医療施設とも連携をとり、患者さんの感染管理・薬の適正使用情報入手・感染防止技術の向上に努めています。
病理検査室
病理検査室では、組織診断、細胞診断、病理解剖を行っています。組織診断では、患者さんから採取された組織(胃、大腸、乳房、皮膚など)から、顕微鏡標本を作製し良性か悪性かまたは病気の種類を診断します。細胞診断では、患者さんから細胞(乳腺の細胞,尿中の細胞、喀痰に含まれる肺の細胞、腹水、胸水中の細胞、子宮頸部、体部の細胞など)を採取して、顕微鏡標本を作製し良性か悪性かを診断します。また、病理解剖では患者さんが亡くなられた時にご遺族の許可を頂いて、亡くなられた原因、病気の種類、治療の効果などを診断します。


